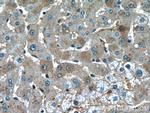
Hemopexin Antibody in Immunohistochemistry (Paraffin) (IHC (P))

Search
Proteintech
Hemopexin Monoclonal Antibody (3A9D6)
{{$productOrderCtrl.translations['antibody.pdp.commerceCard.promotion.promotions']}}
{{$productOrderCtrl.translations['antibody.pdp.commerceCard.promotion.viewpromo']}}
{{$productOrderCtrl.translations['antibody.pdp.commerceCard.promotion.promocode']}}: {{promo.promoCode}} {{promo.promoTitle}} {{promo.promoDescription}}. {{$productOrderCtrl.translations['antibody.pdp.commerceCard.promotion.learnmore']}}
产品信息
66479-1-IG
种属反应
宿主/亚型
分类
类型
克隆号
抗原
偶联物
形式
浓度
规格
纯化类型
保存液
内含物
保存条件
运输条件
产品详细信息
Immunogen sequence: DVTERCSDG WSFDATTLDD NGTMLFFKGE FVWKSHKWDR ELISERWKNF PSPVDAAFRQ GHNSVFLIKG DKVWVYPPEK KEKGYPKLLQ DEFPGIPSPL DAAVECHRGE CQAEGVLFFQ GDREWFWDLA TGTMKERSWP AVGNCSSALR WLGRYYCFQG NQFLRFDPVR GEVPPRYPRD VRDYFMPCPG RGHGHRNGTG HGNSICAVAH I (45-254 aa encoded by BC005395)
靶标信息
Hemopexin is a serum glycoprotein that binds heme and transports it to the liver for breakdown and iron recovery, after which the free hemopexin returns to the circulation. Structurally, hemopexin consists of two similar halves of approximately two hundred amino acid residues connected by a histidine-rich hinge region. Each half is itself formed by the repetition of a basic unit of some 35 to 45 residues.
仅用于科研。不用于诊断过程。未经明确授权不得转售。
生物信息学
蛋白别名: Beta-1B-glycoprotein; epididymis secretory sperm binding protein; Hemopexin; hemopexin precursor; Hyaluronidase; unnamed protein product
基因别名: HPX; Hpxn; HX
UniProt ID: (Pig) P50828, (Human) P02790, (Rat) P20059
Entrez Gene ID: (Pig) 396998, (Human) 3263, (Rat) 58917